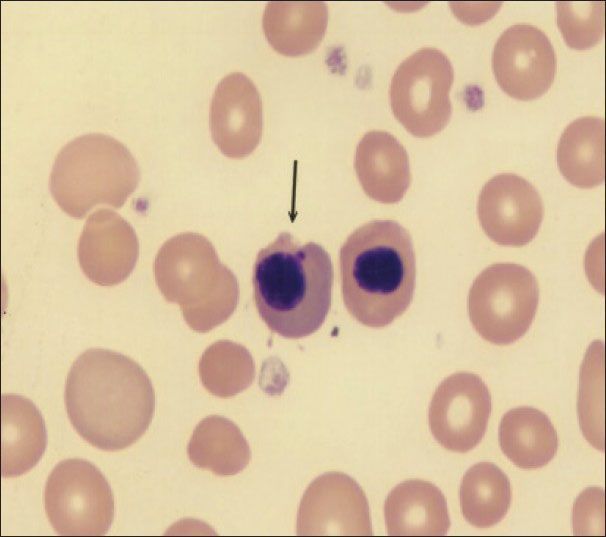

رغم تطور أجهزة #CBC الا ان هناك مصادر أخطاء قد نواجهها اثناء العمل 🔬 يجب معرفتها والانتباه لها ..
في هذا الثريد من اهم ما يمكنك قرءاته عن مصادر الاخطاء و الحلول لها 🍃
#laboratory
#hematology
في هذا الثريد من اهم ما يمكنك قرءاته عن مصادر الاخطاء و الحلول لها 🍃
#laboratory
#hematology
من اهم الاخطاء الي ممكن نواجهها هو ارتفاع او انخفاض بعض
marker of CBC
بالحقيقه هي ليست مرتفعه ولا منخفضه لكن هناك أسباب ادت الى هذا
ونبدأ ب Hb👇
marker of CBC
بالحقيقه هي ليست مرتفعه ولا منخفضه لكن هناك أسباب ادت الى هذا
ونبدأ ب Hb👇
🔴 Falsely high #hemoglobin:
ولأن قياس مستوىHbيعتمد على امتصاصيه الضوء على الطول الموجي 540nm. لذا فإن:
1. العينة Turbid(بسبب ارتفاع عدد WBC count او ارتفاع نسبه الدهون) تسبب في ارتفاع مستوىHb
2. التدخين ايضا يسبب ارتفاع مستوى Hb في الدم بسبب ارتفاع carboxyhemoglobin
ولأن قياس مستوىHbيعتمد على امتصاصيه الضوء على الطول الموجي 540nm. لذا فإن:
1. العينة Turbid(بسبب ارتفاع عدد WBC count او ارتفاع نسبه الدهون) تسبب في ارتفاع مستوىHb
2. التدخين ايضا يسبب ارتفاع مستوى Hb في الدم بسبب ارتفاع carboxyhemoglobin
🔴 Falsely high #MCV:
Cold agglutination
تخثر العينه يقلل عدد خلايا الدم ك عدد
لكنه ك حجم يرتفع حجمها ويسبب ارتفاعMCV
ايضا نتائج PCV, MCH and MCHC
تعتمد على حساب نتائج
Hb, RBCs count and MCV
لذا اذا كان يوجد خطأ في هذه النتائج فيسبب ايضا خطأ في باقي الفحوصات.
Cold agglutination
تخثر العينه يقلل عدد خلايا الدم ك عدد
لكنه ك حجم يرتفع حجمها ويسبب ارتفاعMCV
ايضا نتائج PCV, MCH and MCHC
تعتمد على حساب نتائج
Hb, RBCs count and MCV
لذا اذا كان يوجد خطأ في هذه النتائج فيسبب ايضا خطأ في باقي الفحوصات.
🔴 Falsely high #WBC count:
هناك أسباب عديده ممكن تسبب ارتفاع في خلايا WBCs لكن من اشهر الأسباب:
1. (NRBCs) Nucleated red cell
الحل🍃بطريقتين:
*بواسطه بعض اجهزه CBC بوضع العينه على "NRBC mode"
*إعادة شغل العينه منوال وعد خلاياNRBCs خلال100 خلية WBC
وعمل تصحيح للنتيجة Correction
هناك أسباب عديده ممكن تسبب ارتفاع في خلايا WBCs لكن من اشهر الأسباب:
1. (NRBCs) Nucleated red cell
الحل🍃بطريقتين:
*بواسطه بعض اجهزه CBC بوضع العينه على "NRBC mode"
*إعادة شغل العينه منوال وعد خلاياNRBCs خلال100 خلية WBC
وعمل تصحيح للنتيجة Correction
قانون التصحيح(Correction)
عدد خلايا الدم البيضاء*100 / عدد خلايا NRBC +100
عدد خلايا الدم البيضاء*100 / عدد خلايا NRBC +100
ومن أسباب ارتفاع WBCs
2. Nonlysis of RBCs:
ك Target Cell التي لا تتحلل ويقراءه الجهاز كأنها خلايا WBCs
وهذه الحالة تحدث في أمراض hemoglobinophathies🔽
3.Giant platelets or platelet clumps:
وقد يكون السبب EDTA الحل لهذه الحالة في بعض الأحيان إعادة سحب العينه في انبوبة Citrate
2. Nonlysis of RBCs:
ك Target Cell التي لا تتحلل ويقراءه الجهاز كأنها خلايا WBCs
وهذه الحالة تحدث في أمراض hemoglobinophathies🔽
3.Giant platelets or platelet clumps:
وقد يكون السبب EDTA الحل لهذه الحالة في بعض الأحيان إعادة سحب العينه في انبوبة Citrate
🔴 Falsely increased #Lymphocyte count:
وجود خلايا:
-Giant platelets
-Nonlysis of RBCs
-Nucleated red cell
يقرأها الجهاز ع انها خلايا Lymphocyte مما يسبب في ارتفاع عددها
الحل 🍃
فرد شريحه والتأكيد من عدم وجود هذه الخلايا
وجود خلايا:
-Giant platelets
-Nonlysis of RBCs
-Nucleated red cell
يقرأها الجهاز ع انها خلايا Lymphocyte مما يسبب في ارتفاع عددها
الحل 🍃
فرد شريحه والتأكيد من عدم وجود هذه الخلايا
🔴 Falsely increased #eosinophil count:
1. Neutrophils with hemosiderin granules (counted as eosinophils)
2. Red cells with malarial pigments
خلايا الدم الحمراء المصابه ب ملاريا قد يقراءه الجهاز على انها ايضا خلايا eosinophil
الحل 🍃
فرد شريحه
1. Neutrophils with hemosiderin granules (counted as eosinophils)
2. Red cells with malarial pigments
خلايا الدم الحمراء المصابه ب ملاريا قد يقراءه الجهاز على انها ايضا خلايا eosinophil
الحل 🍃
فرد شريحه
🔴 Falsely high platelet count:
-Fragmented red cells
(in microangiopathic #hemolysis)
-Fragmented white cells
(in #leukemia)
قد يقراءه الجهاز كأنها #platelet
-Fragmented red cells
(in microangiopathic #hemolysis)
-Fragmented white cells
(in #leukemia)
قد يقراءه الجهاز كأنها #platelet
🔴 Falsely low #platelet count:
Agglutination
تخثر العينة من اهم اسباب انخفاض platelets
الحل🍃
إعادة سحب العينه
Agglutination
تخثر العينة من اهم اسباب انخفاض platelets
الحل🍃
إعادة سحب العينه
ويجب أن نعلم أن لا استغناء عن شغل المنوال للتأكد من كل مصادر الاخطاء التي قد تواجهنا في أجهزة ال CBC 🔬
وبهذا وصلنا لنهاية هذا الثريد اتمنى ان يكون مفيد ويساعدنا على شغل افضل ونتائج ادق 🍃
وبهذا وصلنا لنهاية هذا الثريد اتمنى ان يكون مفيد ويساعدنا على شغل افضل ونتائج ادق 🍃
جاري تحميل الاقتراحات...